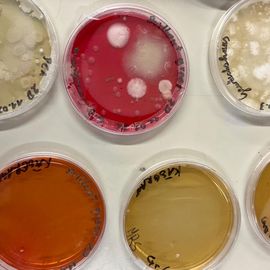

Die Mikrobe des Jahres 2026 ist der Pinselschimmel, wissenschaftlich bekannt als Penicillum . Er ist nicht nur als Produzent des Antibioikums Penicillin bekannt, der als ein zentrales Werkzeug in der Medizin dient, sondern auch als Edelschimmel bei der Käsebereitung eingesetzt wird. In die spannende Welt der Mikroorganismen tauchte die Klasse 2 D bei ihrem Mikrobiologie- Fachtag ein!
Eine Schule der besonderen Art
Fachoberschule für Landwirtschaft Auer
Schlossweg 10, I-39040 Auer, Tel. 0471 81 05 38
E-Mail: os-ofl.auer@schule.suedtirol.it
PEC: ofl.auer@pec.prov.bz.it